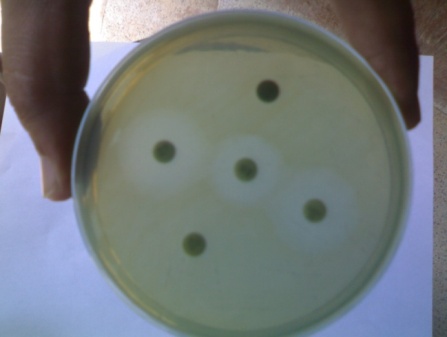
Figure 4 : ?-hemolysis on blood agar Figure 5 : Antibiogram on Nutrient agar On Gram's staining, the bacteria appeared Gram-negative, pink colour, medium size bacilli. Biochemical examination revealed battery of reactions characteristic to Pseudomonas aeruginosa. Based on the zone of inhibition, observations of drug sensitivity tests revealed resistance against amoxicillin+clavulanic acid, enrofloxacin, ofloxacin, levofloxacin, intermediate sensitivity to penicillin, gentamicin and tylosin, and sensitivity to amikacin, ceftriaxone+tazobactum and cefotaxim (Figure 5). The present findings were comparable to the studies conducted by previous researchers (Sun et al., 2011; Ohnishi et al., 2011; Mudau et al., 2013). On the basis of present findings

A Secondary Invader and Cause of Mortality in Foot-and-Mouth Disease Outbreak Amit Kumar Verma ? , Amit Kumar ? , Neha ? , Anu Rahal ? & Basanti Bist ¥ Abstract-Foot-and-mouth disease is a highly contagious viral disease of the cloven-hoofed animals leading to severe economic losses to livestock industry. The disease is clinically characterized by pyrexia, vesicles on the mouth, muzzle, tongue, teats, inter digital space etc with high morbidity and low mortality in affected adults. However, the immunesuppression due to Foot-and-mouth disease virus may lead to development of secondary bacterial infection in the affected animals as a cause of mortality. Many of such secondary bacterial invaders have been reported. The present study revealed Pseudomonas spp. as monoculture from an outbreak leading to mortality in cattle and buffaloes. Pseudomonas aeruginosa, a ubiquitous bacterium, known to cause nosocomial infections such as pneumonia, urinary tract infections, and respiratory system infections are supposed to produce high case fatality rate in immune-suppressed host due to severe toxaemia and drug resistance. The isolates were subjected to antibiotic sensitivity test. Of the 10 antibiotics tested, bacteria were highly resistant to amoxyclav, enrofloxacin, ofloxacin, levofloxacin, intermediate sensitive to penicillins, gentamicin and tylosine, and sensitive to amikacin, ceftriaxone+tazobactum and cefotaxim. The present study concludes that FMD outbreak was followed by secondary bacterial infections of Pseudomonas aeruginosa, which might have entered in the circulation through the lesions in tongue and foot. Moreover, immunosuppression due to FMD further led to colonization of Pseudomonas aeruginosa in critical body organs, such as the lungs, heart and kidney leading to severe mortality. Hence, the control of secondary invaders should be considered on priority to avoid the mortality in the outbreak situations.
Introduction oot-and-mouth disease (FMD) is a highly contagious and devastating viral disease of the cloven-hoofed animals including cattle and buffaloes; and considered as a serious threat to the economy of the livestock industry all over the world the world (Verma et al., 2008 to adherence of Pseudomonas with the skin surface and may contaminate the wound and form abscess. Drug resistance of the organism supports bacterial survival in wounds and further entry in circulation leading to involvement of multiple system viz., respiratory and urinary tracts. In advanced stages of the infection severe toxaemia leads to mortality. Hence, the aim of the present study was to reveal the cause of mortality in cattle and buffaloes following to an outbreak of FMD disease in Chandauli district of Uttar Pradesh state, India.
The incidence occurred in village Daina, district Chandauli, Uttar Pradesh, India. At the time of incidence the population of dairy animals (cattle and buffaloes) in the village was approximately 1200. The animals were kept individually or in groups. The animal rearing practices included stall feeding of wheat/paddy straw, concentrate, and mineral mixture with ad lib water Go-Anusandhan Sansthan (DUVASU), Mathura, India. The health and basic record books of the herd, compiled by veterinary and animal care staff, were also examined and analysed for occurrence of the disease, morbidity and mortality etc. All the animals were having the history of vaccination with Pasteurella multocida biotype A vaccine (Biological Product Section, Badshabagh, Lucknow). However, FMD vaccination was lacking in the village. The area was having the history of flood or water logging nearly two months prior to outbreak. The hygiene and sanitation conditions in the villages were unsatisfactory. Majority of the animals were suffering with pyrexia, vesicular lesions in teats and foot (Figure 2 and 3) and respiratory distress. The morbidity and mortality rate was quite high with the death of large number of animals. The clinical signs and history were suggestive of Foot-and-Mouth Disease.
In the present study, clinical signs of the animals were indicative of Foot-and-Mouth Disease. On retrospective study, the sera samples showed high titre against FMDV serotype 'O' suggesting the infection of serotype 'O' of FMD virus. However, there is as such no report of high mortality due to FMD in cattle and particularly in buffaloes. Serotype 'O' is predominantly causes FMD in cattle but in this outbreak high titre against FMDV serotype 'O' in buffaloes also suggest some antigenic alteration or host adaptability of preexisting serotype 'O' virus in India. There are previous studies reporting the high prevalence of FMDV serotype 'O' in Uttar Pradesh state, India (Verma et al., 2008). The involvement of buffaloes in such outbreaks with higher rate of mortality than cattle is of major concern as buffaloes were suggested to show clinical signs less commonly as compared to cattle (Chakraborty et al., 2014). Moreover, India is having the largest population of buffaloes, accounting for nearly 57% of the world buffalo population, and buffaloes are considered as back bone of rural economy (Kumar, 2005).
Monoculture Pseudomonas aeruginosa was isolated from blood. The isolated bacteria were found to be motile, produced characteristics colonies in nutrient agar along with pigmentation, showed ?-hemolysis on blood agar (Figure 4) and grew on MacConkey agar. Mudau et al., 2013). On the basis of present findings inference can be drawn that it was an outbreak of FMD, followed by secondary bacterial infection of Pseudomonas aeruginosa, which might have entered in the circulation through the lesions in foot, tongue and teats. Moreover, immunosuppression due to FMD further led to colonization of Pseudomonas aeruginosa in critical body organs, such as the lungs, heart and kidney leading to severe mortality. On the basis of results of antibiotic sensitivity testing, the authors suggested amikacin, ceftriaxone + tazobactum and cefotaxim for the treatment of affected animals and after treatment with these drugs the mortality among animals was controlled in the village.
It can be concluded that occurrence of FMD leads to immunosuppression making affected animals more susceptible and prone to nosocomial infections viz. Pseudomonas aeruginosa. The drug sensitivity pattern revealed that isolates were resistant to many of commonly used broadspectrum antibiotics which might be the cause of failure of treatment. However, antibacterial like amikacin, ceftriaxone + tazobactum and cefotaxim appeared to be drugs of choice for the treatment of Pseudomonas infection as the recommendation of these drugs controlled the mortality of animals in the village. Hence, the control of secondary invaders should be considered on priority to avoid the mortality in the outbreak situations.
V.

Authors are highly thankful to Dean, College of Veterinary Science and Animal Husbandry, and Hon'ble Vice Chancellor, DUVASU, Mathura, India; for providing all the necessary support and facilities. Authors are also thankful to officials of Department of Animal Husbandry, Uttar Pradesh, technical staff of Department of Veterinary Epidemiology & Preventive Medicine and Veterinary Microbiology for their assistance.
Studies of the outbreaks of footand-mouth disease in. Asian J. Epidemiol 2008. 2000 and 2006. 1 (2) p. .
Phylogenetic relationships between foot-and-mouth disease virus serotype 'A' isolates and vaccine strains. Online J Vet Res 2010a. 14 (1) p. .
Differentiation of Foot-and-Mouth Disease infected and vaccinated animals using 3ABC non-structural protein. Indian Journal of Veterinary Medicine 2010b. 30 (2) p. .
Epidemiology and diagnosis of foot and mouth disease: a review. Ind. J. Anim. Sci 2012. 82 (6) p. .
Antibiotic susceptibility testing by a standardized single disc method. Am. J. Clin. Pathol 1996. 145 p. .
A new enzyme-linked immunosorbent assay (ELISA) for the detection of antibodies against footand-mouth disease virus. I. Development and method of ELISA. J Immunol Methods 1986. 93 p. .
Pneumonia due to Pseudomonas aeruginosa: part II: antimicrobial resistance, pharmacodynamic concepts, and antibiotic therapy. Chest 2011. 139 (5) p. .
Development of vaccines toward the global control and eradication of foot-and-mouth disease. Expert Rev. Vaccines 2011. 10 (3) p. .
Development of a universal RT-PCR for amplifying and sequencing the leader and capsid-coding region of foot-and-mouth disease virus. J. Virol. Meth 2013. 189 (1) p. .
Myocarditis Associated with Foot-and-Mouth Disease Virus Type O in Lambs. Veterinary Pathology 2007. 44 p. .
Epidemiology of burn unit infections in children. American Journal Infected Control 2003. 6 p. .
Outbreak of Multi-Drug Resistant Pseudomonas aeruginosa Bloodstream Infection in the Haematology Unit of a South African Academic Hospital. PLoS One 2013. 8 (3) p. e55985.
Antimicrobial susceptibilities and bacteriological characteristics of bovine Pseudomonas aeruginosa and Serratia marcescens isolates from Mastitis. Veterinary Microbiology 2011. 154 p. .
Genetic and antigenic relationship between foot and mouth disease virus serotype Asia-1 isolate and vaccine strain. Online J Vet Res 2009. 13 (2) p. .
Performance standards for antimicrobial disk and dilution susceptibility tests for bacteria isolated from animals: approved standard M31-A2. NCCLS 2002. National Committee for clinical Laboratory Standards (2nd Edn.)
Foot-and-Mouth disease, an economically important disease of animals. Adv. Anim. Vet. Sci 2014. 2 (2S) p. .
An overview of control strategy and diagnostic technology for footand-mouth disease in China. Virol. J 2013. 10 (1) p. 78.